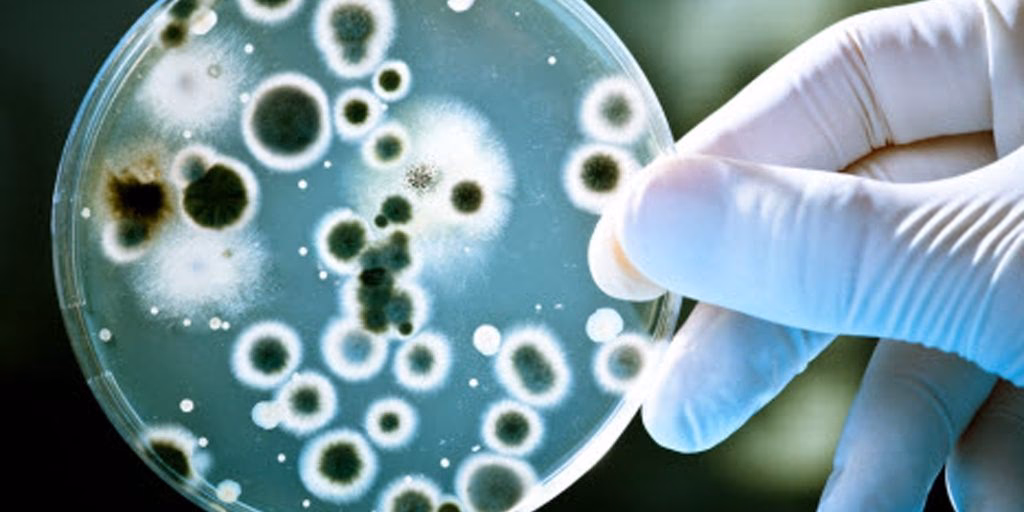
¿Cuál es el objetivo del descubrimiento del agente patógeno?

29/10/2021
En el vasto y complejo tapiz de la vida en la Tierra, existen actores tan pequeños que son invisibles a nuestros ojos, pero cuyo impacto es monumental. Hablamos de los agentes patógenos, entidades biológicas que, a pesar de su tamaño microscópico, tienen el poder de alterar la salud de individuos, poblaciones enteras y hasta el equilibrio de ecosistemas completos. El término patógeno proviene del griego: pathos (enfermedad) y geno (producir). Literalmente, son los "productores de enfermedades". Aunque a menudo los asociamos exclusivamente con la salud humana, su rol en el medio ambiente es profundo y multifacético, actuando como reguladores naturales, pero también como amenazas exacerbadas por la actividad humana. Este artículo se adentra en el mundo de los patógenos para entender qué son, cómo se clasifican y, fundamentalmente, cuál es su intrínseca relación con el medio ambiente que nos rodea.

¿Qué es Exactamente un Agente Patógeno?
Un agente patógeno es cualquier microorganismo o entidad biológica capaz de causar una enfermedad o daño en un organismo huésped, ya sea una planta, un animal o un ser humano. Es crucial entender que no todos los microorganismos son dañinos. De hecho, nuestro planeta y nuestros propios cuerpos albergan billones de microorganismos beneficiosos y esenciales para la vida. Por ejemplo, la microbiota intestinal humana es fundamental para la digestión y la protección contra, precisamente, otros organismos dañinos. Un microorganismo se convierte en patógeno por su capacidad de invadir al huésped, multiplicarse en su interior y alterar su fisiología normal, a menudo produciendo toxinas o provocando una respuesta inmunitaria que termina por dañar los propios tejidos del huésped.
La Diversa Familia de los Patógenos
Los agentes que producen enfermedades no son un grupo homogéneo. Se clasifican en varias categorías principales, cada una con características, mecanismos de acción y nichos ecológicos distintos.
Bacterias: Maestras de la Adaptación
Las bacterias son organismos unicelulares procariotas presentes en casi todos los hábitats de la Tierra. Mientras muchas son inofensivas o beneficiosas, algunas especies son patógenas notorias. Pueden causar enfermedades al competir con las células del huésped por los nutrientes, liberando toxinas (endotoxinas y exotoxinas) o invadiendo y destruyendo tejidos directamente. Ejemplos comunes incluyen Salmonella, que causa intoxicaciones alimentarias, Mycobacterium tuberculosis, el agente causal de la tuberculosis, y Escherichia coli, algunas de cuyas cepas pueden provocar graves infecciones intestinales.
Virus: Parásitos Intracelulares Obligados
Los virus son aún más pequeños que las bacterias y se encuentran en la frontera entre lo vivo y lo inerte. No son células completas; consisten en material genético (ADN o ARN) envuelto en una cubierta de proteína. Para replicarse, necesitan secuestrar la maquinaria celular de un huésped. Son responsables de una amplia gama de enfermedades, desde el resfriado común (causado por Rinovirus) hasta pandemias globales como la gripe (virus Influenza) o la COVID-19 (SARS-CoV-2), pasando por enfermedades crónicas como el SIDA (VIH).

Hongos: Patógenos Oportunistas
Aunque el reino Fungi es conocido por sus roles ecológicos en la descomposición y por alimentos como las setas, algunas especies pueden causar enfermedades, conocidas como micosis. A menudo actúan como patógenos oportunistas, afectando principalmente a individuos con sistemas inmunitarios debilitados. Ejemplos incluyen Candida albicans, causante de la candidiasis, y Aspergillus fumigatus, que puede provocar infecciones pulmonares graves (aspergilosis).
Protozoos y Parásitos: Los Huéspedes Complejos
Esta categoría incluye organismos eucariotas unicelulares (protozoos) y multicelulares (helmintos o gusanos). Su ciclo de vida suele ser complejo, involucrando a menudo a más de un huésped. Plasmodium falciparum, un protozoo transmitido por mosquitos, es el causante de la malaria, una de las enfermedades más mortales de la historia. Por otro lado, gusanos como la tenia (Taenia solium) pueden alojarse en el tracto digestivo, absorbiendo nutrientes a expensas del huésped.
Tabla Comparativa de Agentes Patógenos
| Tipo de Patógeno | Estructura | Reproducción | Ejemplo de Enfermedad |
|---|---|---|---|
| Bacteria | Unicelular Procariota | Fisión binaria | Tuberculosis, Salmonelosis |
| Virus | Material genético + Proteína | Replicación dentro de una célula huésped | Gripe, COVID-19, VIH/SIDA |
| Hongo | Unicelular o Multicelular Eucariota | Esporas, gemación | Candidiasis, Pie de atleta |
| Protozoo | Unicelular Eucariota | Fisión, ciclos complejos | Malaria, Giardiasis |
El Ecosistema como Reservorio y Vector
La ecología de los patógenos es fundamental para entender cómo surgen y se propagan las enfermedades. Los patógenos no existen en el vacío; son parte integral de los ecosistemas y sus ciclos de vida están intrínsecamente ligados al entorno.

- Agua Contaminada: El agua es uno de los vehículos de transmisión más eficientes. Ríos, lagos y fuentes subterráneas contaminadas con heces humanas o animales pueden albergar bacterias como Vibrio cholerae (cólera) o protozoos como Giardia lamblia. La falta de saneamiento y de acceso a agua potable es una de las principales causas de enfermedades infecciosas a nivel mundial.
- Suelo: El suelo es un reservorio masivo de vida microbiana. Puede albergar esporas de bacterias como Clostridium tetani (tétanos), que ingresan al cuerpo a través de heridas, o esporas de hongos que pueden ser inhaladas.
- Aire: Muchos virus respiratorios, como los de la gripe y los coronavirus, se transmiten a través de gotículas que se expulsan al toser o estornudar, permaneciendo suspendidas en el aire, especialmente en espacios cerrados y mal ventilados.
- Alimentos: La cadena alimentaria es otra vía crucial. La manipulación inadecuada o la cocción insuficiente de alimentos pueden transmitir bacterias como Salmonella y Campylobacter, presentes en carnes crudas, o virus como el Norovirus.
- Zoonosis y Vectores: Se estima que más del 60% de las enfermedades infecciosas humanas son de origen animal (zoonosis). La transmisión puede ocurrir por contacto directo o a través de un vector, como un mosquito que transmite el virus del Dengue o la garrapata que transmite la bacteria de la enfermedad de Lyme. La deforestación, la expansión urbana y el cambio climático alteran los hábitats, aumentando el contacto entre humanos, ganado y vida silvestre, lo que facilita el "salto" de patógenos entre especies.
Impacto Humano y Desequilibrio Ecológico
Las actividades humanas están alterando drásticamente la dinámica de los patógenos. El cambio climático, por ejemplo, está expandiendo el rango geográfico de vectores como los mosquitos, llevando enfermedades como la malaria y el dengue a nuevas regiones. El uso excesivo de antibióticos en la medicina y la ganadería está impulsando la aparición de "superbacterias" resistentes, una de las mayores amenazas para la salud global. La contaminación de los ecosistemas acuáticos con nutrientes puede provocar la proliferación de algas nocivas y bacterias patógenas.
Preguntas Frecuentes (FAQ)
¿Todos los microorganismos son patógenos?
No, en absoluto. La inmensa mayoría de los microorganismos en la Tierra son inofensivos o beneficiosos. Desempeñan roles vitales como la descomposición de materia orgánica, la producción de oxígeno y el mantenimiento de la salud de nuestro sistema digestivo. Los patógenos son solo una pequeña fracción del mundo microbiano.

¿Cómo podemos protegernos de los patógenos ambientales?
Las medidas clave incluyen una buena higiene personal (lavado de manos), el consumo de agua potable y alimentos debidamente cocinados y manipulados, la vacunación para prevenir enfermedades específicas y el control de vectores como los mosquitos en nuestro entorno.
¿Qué es la virulencia de un patógeno?
La virulencia se refiere al grado de patogenicidad de un microorganismo, es decir, su capacidad para causar daño al huésped. Un patógeno altamente virulento tiene más probabilidades de causar una enfermedad grave. Este factor puede variar enormemente incluso dentro de la misma especie de patógeno.

¿El cambio climático realmente influye en las enfermedades infecciosas?
Sí, de manera significativa. El aumento de las temperaturas y los cambios en los patrones de lluvia pueden expandir el hábitat de vectores como mosquitos y garrapatas. Además, los eventos climáticos extremos, como inundaciones, pueden contaminar las fuentes de agua y aumentar el riesgo de brotes de enfermedades transmitidas por el agua.
Conclusión: Una Perspectiva de Salud Planetaria
Comprender a los agentes patógenos va más allá de la microbiología clínica; es una cuestión de ecología y salud planetaria. Estos organismos invisibles nos recuerdan que la salud humana está inseparablemente ligada a la salud de los ecosistemas. La prevención de futuras pandemias y el control de enfermedades infecciosas existentes no solo dependen de avances médicos, sino también de la conservación de la biodiversidad, la gestión sostenible de los recursos naturales y la lucha contra el cambio climático. Reconocer nuestro lugar en la red de la vida y actuar para mantener su equilibrio es, en última instancia, la mejor defensa contra las amenazas que, aunque invisibles, tienen el poder de cambiar nuestro mundo.
Si quieres conocer otros artículos parecidos a Patógenos: La Amenaza Invisible en el Ecosistema puedes visitar la categoría Ecología.
